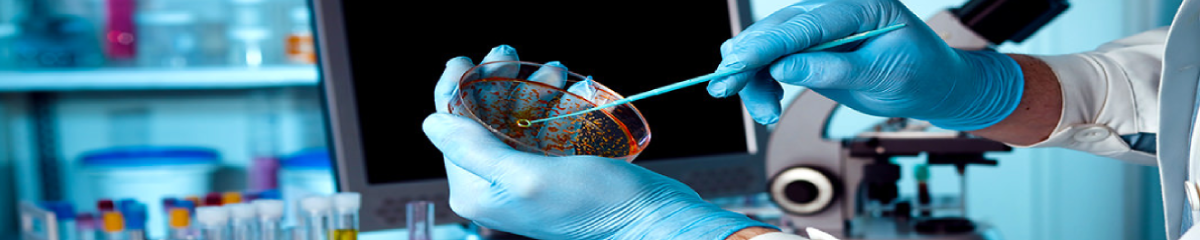
Τμήμα Μικροβιολογίας

Η μελέτη των μολυσματικών ασθενειών αποτελεί μια σημαντική δραστηριότητα του ΕΙΠ, με πρωτοποριακή συνεισφορά στο πεδίο. Το ΕΙΠ χαίρει εθνικής και διεθνούς αναγνώρισης για την υψηλού επιπέδου, ανταγωνιστική έρευνα σε συγκεκριμένους τομείς της Μικροβιολογίας. Ειδικότερα, η έρευνα στη μικροβιολογία αφορά σε έναν επιλεγμένο αριθμό σημαντικών παθογόνων με υψηλό κοινωνικο-οικονομικό αντίκτυπο σε εθνικό και ευρωπαϊκό επίπεδο. Μεταξύ αυτών περιλαμβάνονται: ο ιός της ηπατίτιδας C, (HCV), οι ερπητοϊοί, τα πρωτοζωικά παράσιτα Leishmania και Trypanosoma brucei, Gram- νοσοκομειακά παθογόνα, Neissseria gonorrhoeae, Chlamydia και Helicobacter pylori.
Η έρευνα σε αυτό το πεδίο εστιάζεται στα:
- Mοριακή και κυτταρική βιολογία των προαναφερθέντων παθογόνων, με ιδιαίτερη έμφαση στον προσδιορισμό μορίων που επηρεάζουν την ανάπτυξη και τη μολυσματικότητά τους
- Μηχανισμούς που διέπουν την αλληλεπίδραση παθογόνου-ξενιστή και καθορίζουν την εξέλιξη της ασθένειας, με ιδιαίτερη έμφαση στους μηχανισμούς διαφυγής του παθογόνου από την επιτήρηση του ανοσολογικού συστήματος
- Προσδιορισμό των βασικών μορίων που εμπλέκονται στην αλληλεπίδραση παθογόνου-ξενιστή με στόχο την αποκάλυψη νέων θεραπευτικών στόχων για την ανάπτυξη αντιμικροβιακών ενώσεων ή/και ανοσοθεραπευτικών ή προφυλακτικών εμβολίων, καθώς και τη βελτίωση διαγνωστικών εργαλείων για την πρόληψη και τον έλεγχο μολυσματικών ασθενειών
- Μελέτες στο αντικείμενο της αντοχής των βακτηρίων στα αντιβιοτικά, με έμφαση στην ανάλυση των βιοχημικών, μοριακών και γενετικών μηχανισμών που υποστηρίζουν την εκδήλωση της αντοχής στα βακτήρια, αλλά και στην παρακολούθηση των επιδημιολογικών τάσεων τη βακτηριακής αντοχής. Η έρευνα στο πεδίο αυτό είναι σημαντική για το σχεδιαμό νέων αντιβιοτικών και θεραπευτικών προσεγγίσεων για την αντιμετώπιση των λοιμώξεων από πολυανθεκτικά βακτήρια, καθώς και για την μεθόδευση στρατηγικής στη χρήση των ήδη διαθέσιμων αντιβιοτικών που να συντηρεί την αποτελεσματικότητά τους.
- Την ανάπτυξη μοριακών εργαλείων για τη διάγνωση, την τυποποίηση και τη γενετική ανάλυση του πληθυσμού ιικών, βακτηριακών και παρασιτικών μολύνσεων και την εφαρμογή τους στα εργαστήρια δημόσιας υγείας.
Ένας αριθμός ερευνητικών δραστηριοτήτων του Τμήματος σχετικά με τους ιούς, τα βακτήρια και τα παράσιτα συμβάλλουν σε δραστηριότητες παροχής υπηρεσιών στο διαγνωστικό τμήμα και τα εργαστήρια του τομέα δημόσιας υγείας. Μια τέτοια αλληλεπίδραση ασκεί σημαντική επίδραση στην ανάπτυξη της έρευνας και των υπηρεσιών του ΕΙΠ που προσδίδει μοναδικά χαρακτηριστικά στο ΕΙΠ σε σχέχη με άλλα άλλα ερευνητικά κέντρα της Χώρας που δραστηριοποιούνται στις λοιμώξεις.











Τιμοκράτης Καραμήτρος











